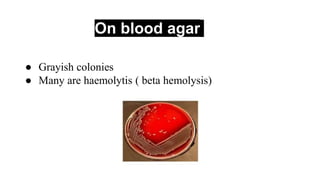
On blood agar
● Grayish colonies
● Many are haemolytis ( beta hemolysis)
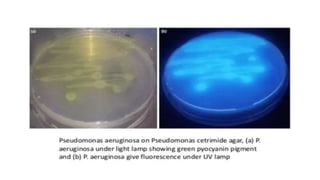
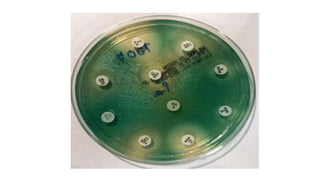

The document provides an in-depth overview of Pseudomonas aeruginosa, covering its taxonomy, pathogenicity, morphology, cultural characteristics, clinical symptoms, diagnosis, and treatment. It highlights the bacterium's role in opportunistic infections, especially in hospitalized patients, and details its biochemical properties, growth requirements, and resistance to antibiotics. The document also discusses prevention measures and treatment options for infections caused by P. aeruginosa.